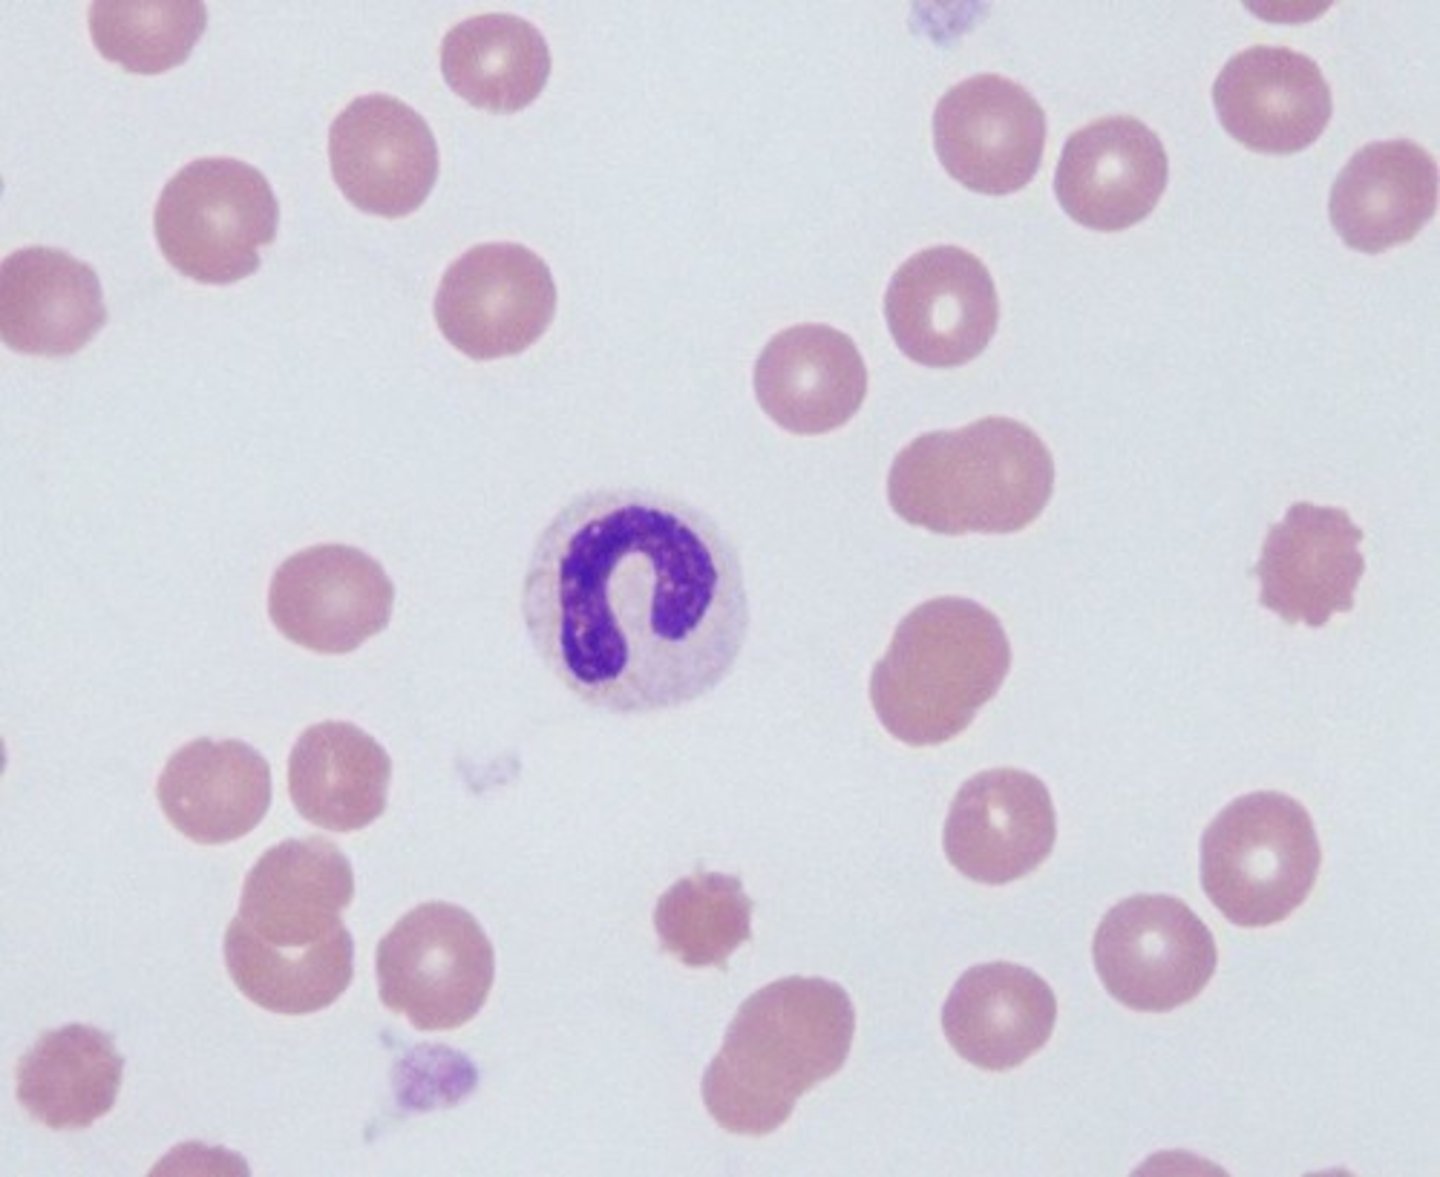
<p>- Indented nucleus >50% w/o filament</p><p>- Coarse, clumped chromatin</p><p>- Pale pink cytoplasm</p><p>- Secondary granules</p><p>- 1:2 N:C ratio</p>
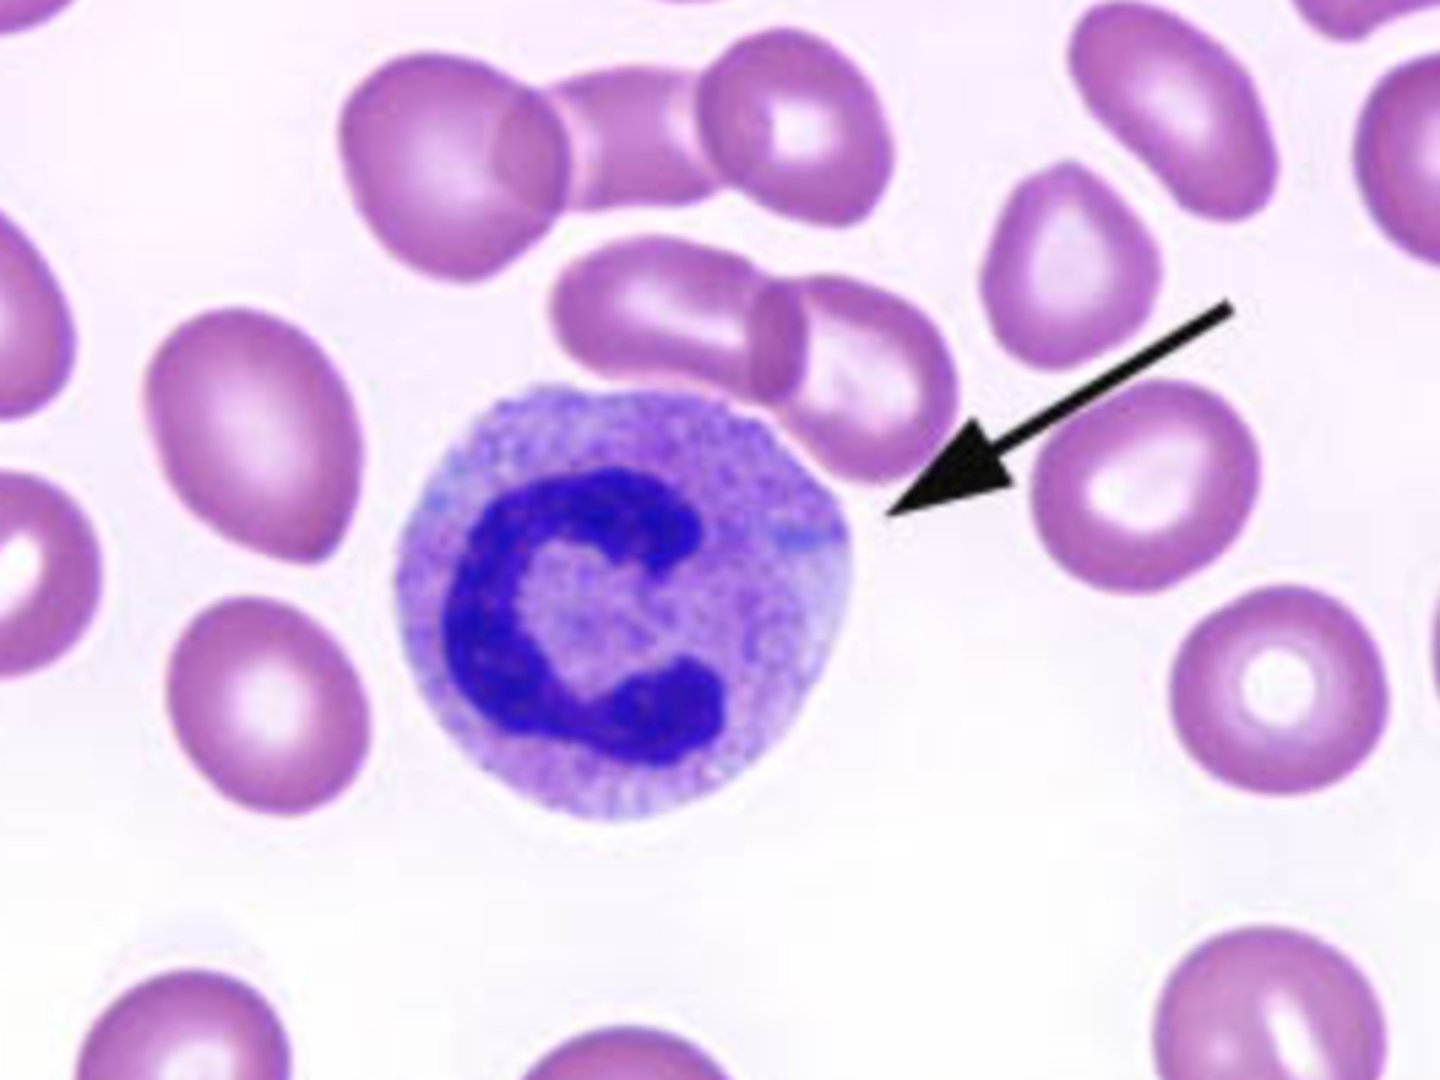
<p>- Gray-blue, variable-shaped inclusions in cytoplasm</p>
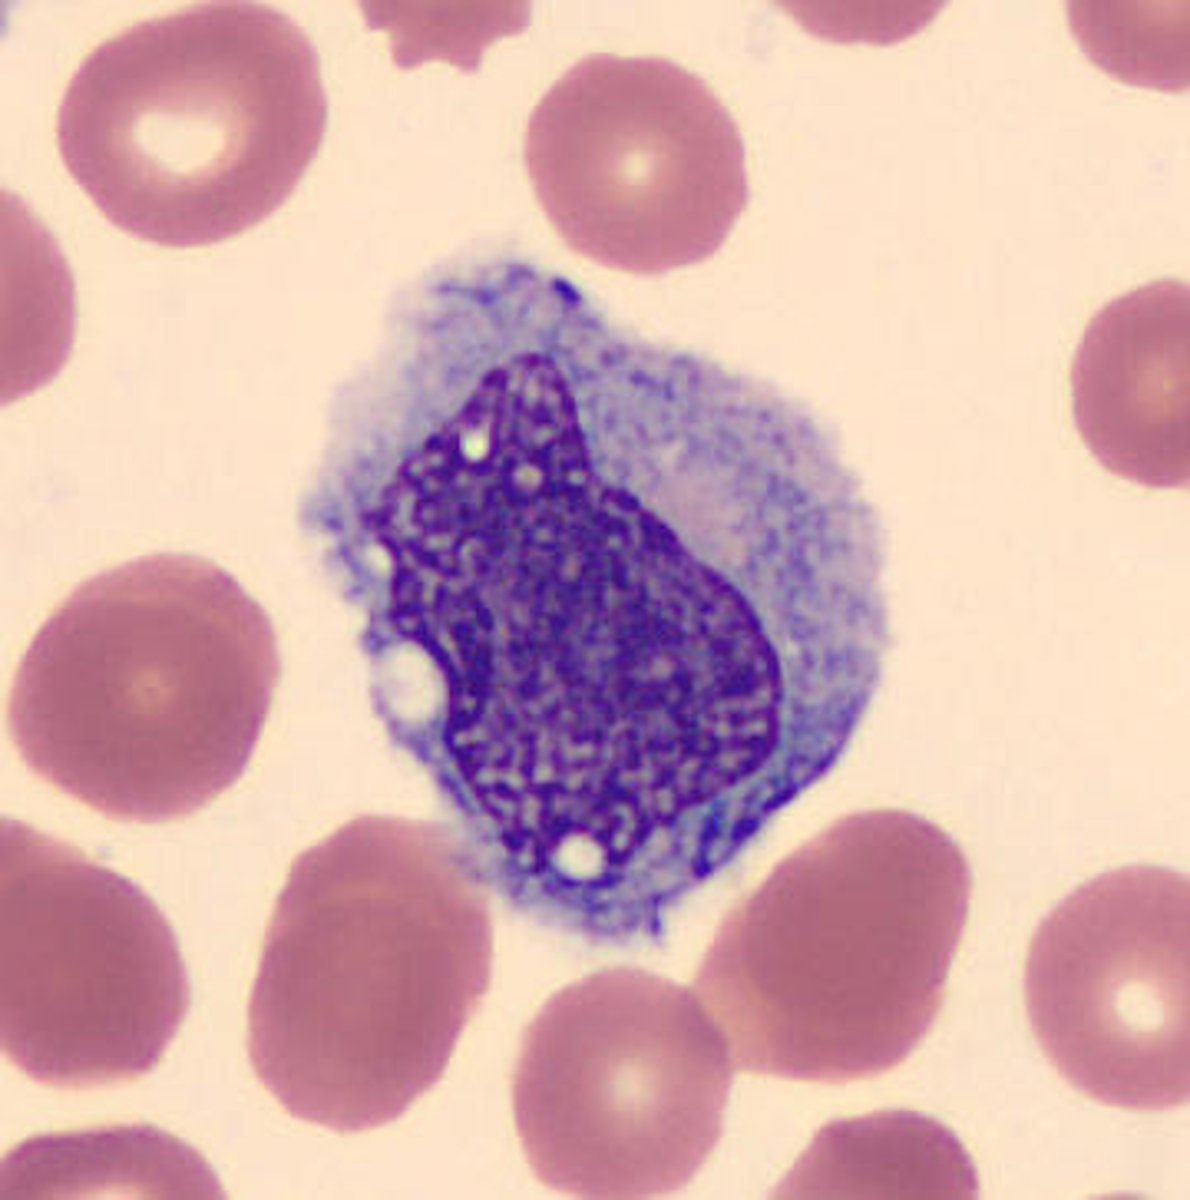
<p>- Horseshoe-shaped, indented</p><p>- Round to oval nucleus</p><p>- Nuclear folding sometimes</p><p>- Vacuoles present</p><p>- Lacy chromatin</p><p>- Gray, gray-blue, ground glass appearance</p><p>- Fine, pale pink, dust-like granules evenly dispersed</p><p>- 4:2-2:1 N:C ratio</p>
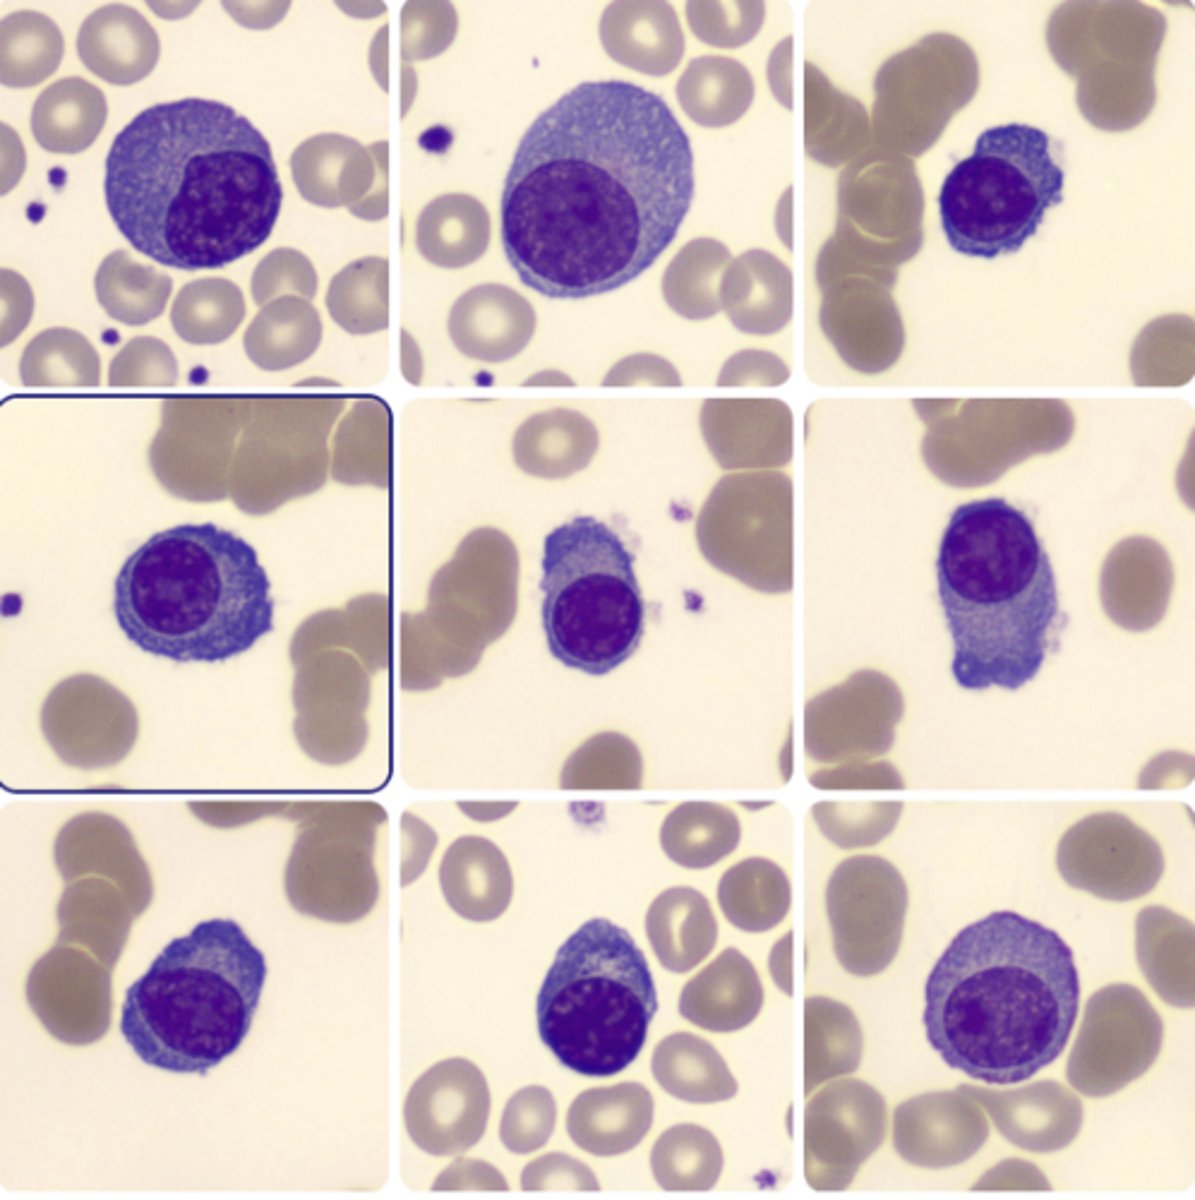
<p>- Round, ovoid eccentric nucleus</p><p>- Clumped chromatin, no nucleoli</p><p>- Abundant, deep-blue cytoplasm w/ clear area next to nucleus</p><p>- 1:2 N:C ratio</p>
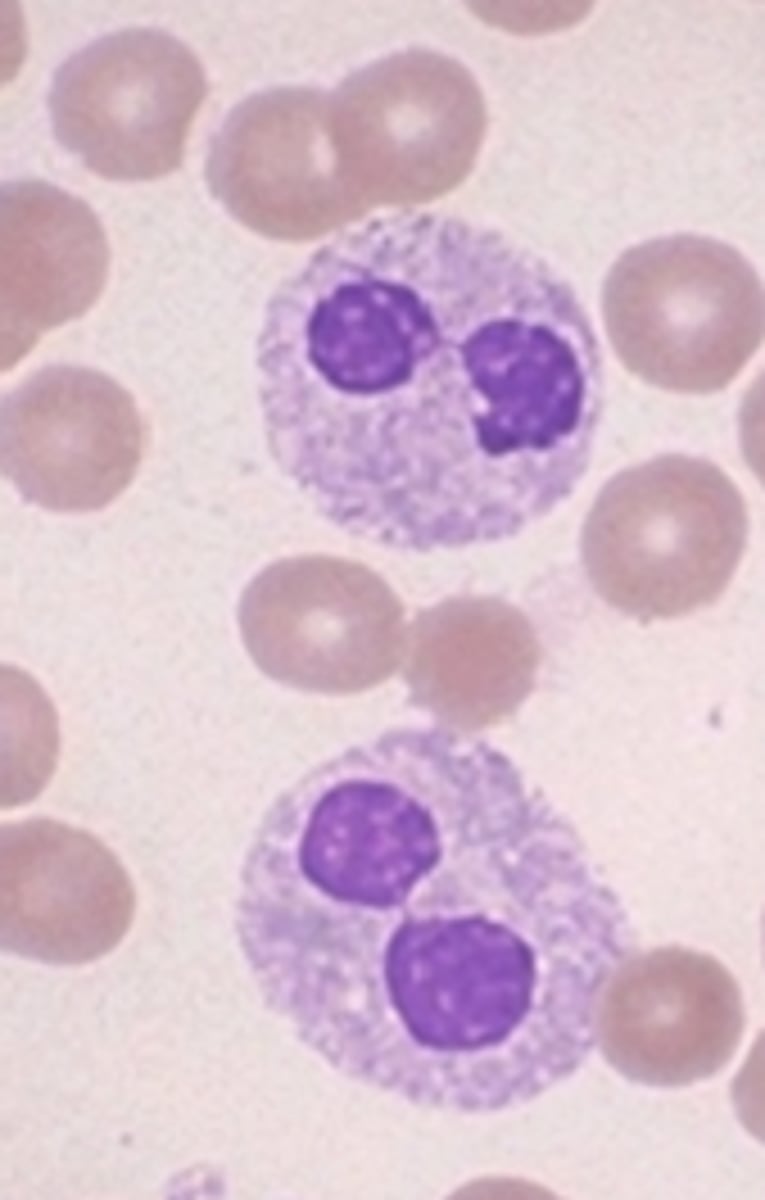
<p>- Peanut-shaped, bilobed, or non-segmented granulocyte</p>
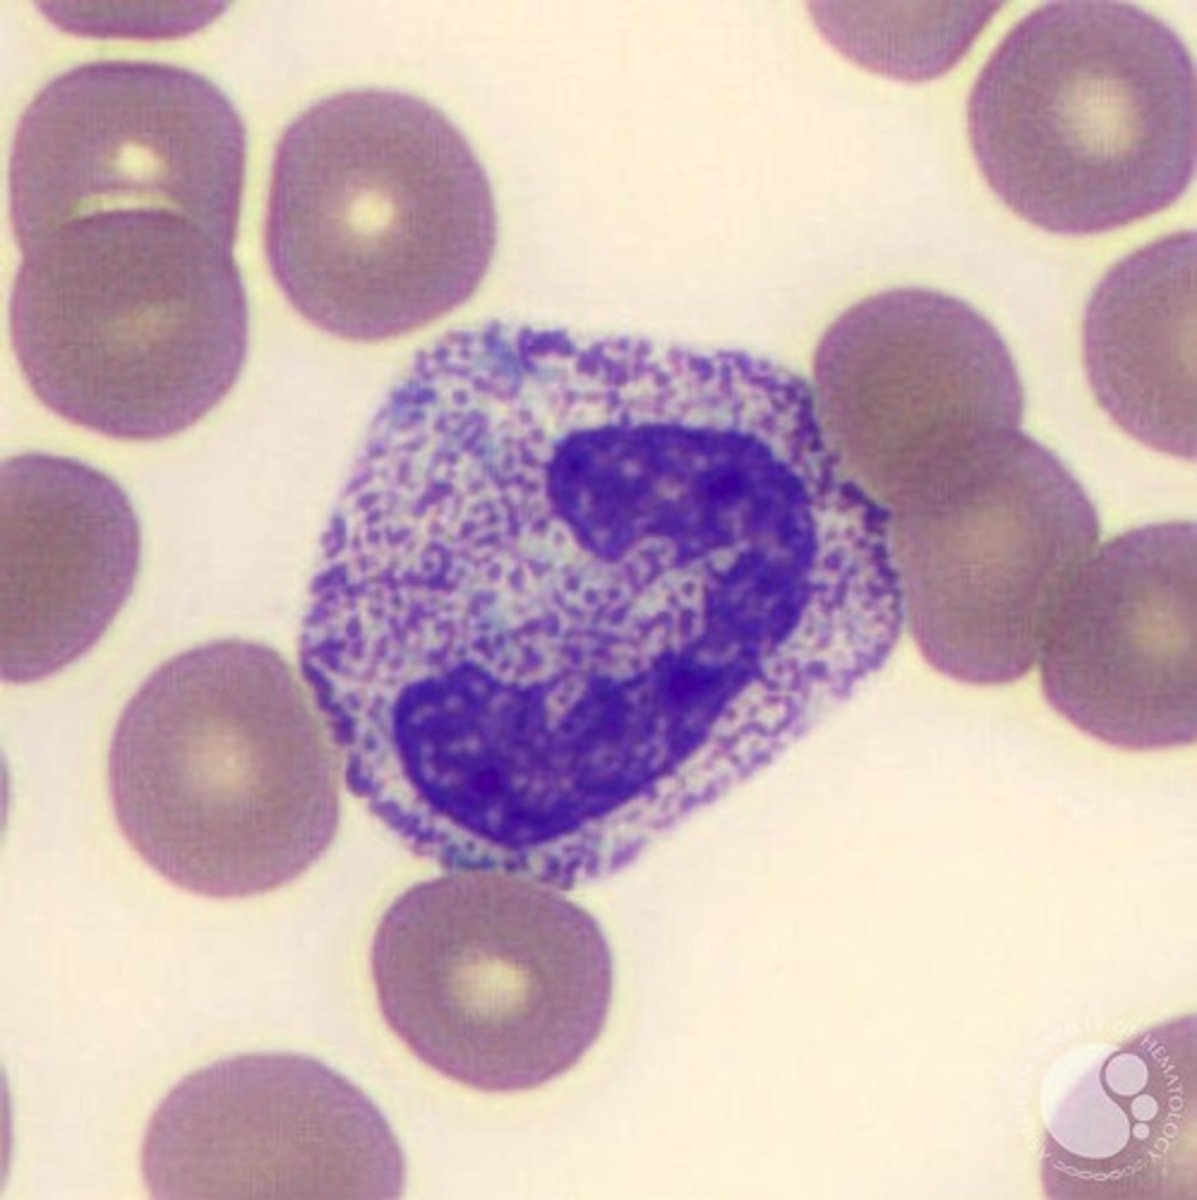
<p>- Dark purple-black primary granules in cytoplasm of neutrophils</p>

Hematology WBC Morphology Identification
1/18
There's no tags or description
Looks like no tags are added yet.
Name | Mastery | Learn | Test | Matching | Spaced | Call with Kai |
|---|
No analytics yet
Send a link to your students to track their progress
19 Terms
Auer Rods
- Needle-shaped rods
- Red-purple inclusions
- Found in leukemic myeloblasts & promyelocytes
- Made of fused lysosomes, peroxidase and lysosomal enzymes

Banded Neutrophil
- Indented nucleus >50% w/o filament
- Coarse, clumped chromatin
- Pale pink cytoplasm
- Secondary granules
- 1:2 N:C ratio
Basophil
- Clumped chromatin, no nucleoli
- 1:2 - 1:3 N:C ratio
- Segmented nucleus, obscured by granules
- Large, blue-black, purple-red granules

Blast
- Round or oval nucleus
- Finely, reticulated chromatin
- 3-5 large nucleoli, can be single, large, & centrally located
- Scant, dark-blue cytoplasm w/ no granules
- 7:1-5:1 N:C ratio

Dohle Bodies
- Gray-blue, variable-shaped inclusions in cytoplasm
Eosinophil
- 1:3 N:C ratio
- Clumped chromatin, no nucleoli
- Large, orange-red granules

Hypersegmented Neutrophil
- Neutrophils with 5 or more lobed nuclei

Lymphocyte
- Round to ovoid nucleus
- Dense, clumpy, condensed chromatin
- 5:1-2:1 N:C ratio
- Scant amounts of pale blue to moderately basophilic cytoplasm

Metamyelocyte
- Indented <50% Nucleus
- Moderately clumped cytoplasm
- Pale pink to cream-colored cytoplasm
- Secondary granules
- 1.5:1 - 1:1 N:C Ratio

Myelocyte
- Round to oval nucleus
- Coarse chromatin
- Slight blue to cream-colored cytoplasm
- Primary & secondary granules
- 2:1 N:C Ratio

Monocyte
- Horseshoe-shaped, indented
- Round to oval nucleus
- Nuclear folding sometimes
- Vacuoles present
- Lacy chromatin
- Gray, gray-blue, ground glass appearance
- Fine, pale pink, dust-like granules evenly dispersed
- 4:2-2:1 N:C ratio
Plasma Cell
- Round, ovoid eccentric nucleus
- Clumped chromatin, no nucleoli
- Abundant, deep-blue cytoplasm w/ clear area next to nucleus
- 1:2 N:C ratio
Pelger-Huët Cell (Hyposegmented Neutrophil)
- Peanut-shaped, bilobed, or non-segmented granulocyte
Promyelocyte
- Fine, slightly coarse chromatin
- Basophilic cytoplasm
- Round to oval nucleus
- 1-3+ nucleoli present
- Auer rods may be present

Pyknotic Cell
- Degenerating cells
- Variable nuclear shape
- Multiple lobes, varying in size and shape w/o connecting filaments
- Dark, homogenous, dense chromatin

Reactive Lymphocyte
- Pleomorphic
- Easily indented by surrounding cells
- Irregular nucleus
- Occasional nucleoli
- Coarse to fine & dispersed chromatin
- Can have vacuoles or azurophilic granules

Segmented Neutrophil
- Highly condensed nuclear chromatin
- Segmented/lobated nucleus (3-5 lobes)
- Connected by thin filament
- Pale, pink cytoplasm
- 1:3 N:C ratio

Toxic Granulation
- Dark purple-black primary granules in cytoplasm of neutrophils
Vacuolated Neutrophil w/ Toxic Granulation
- Unstained circular area within cytoplasm
- Associated with bacterial or fungal infections when seen with neutrophils
